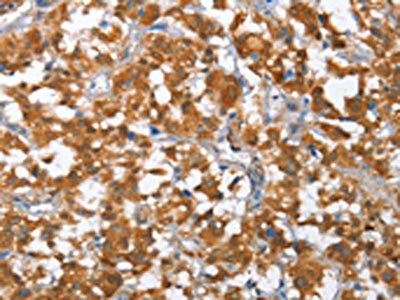

TP53BP2 Antibody
-
中文名稱:TP53BP2兔多克隆抗體
-
貨號:CSB-PA948343
-
規格:¥1100
-
圖片:
-
The image on the left is immunohistochemistry of paraffin-embedded Human thyroid cancer tissue using CSB-PA948343(TP53BP2 Antibody) at dilution 1/35, on the right is treated with fusion protein. (Original magnification: ×200)
-
The image on the left is immunohistochemistry of paraffin-embedded Human brain tissue using CSB-PA948343(TP53BP2 Antibody) at dilution 1/35, on the right is treated with fusion protein. (Original magnification: ×200)
-
Gel: 10%SDS-PAGE, Lysate: 40 μg, Lane 1-3: Mouse kidney tissue, 293T cells, 231 cells, Primary antibody: CSB-PA948343(TP53BP2 Antibody) at dilution 1/375, Secondary antibody: Goat anti rabbit IgG at 1/8000 dilution, Exposure time: 30 seconds
-
-
其他:
產品詳情
-
Uniprot No.:
-
基因名:
-
別名:53BP2 antibody; Apoptosis stimulating of p53 protein 2 antibody; Apoptosis stimulating protein of p53 2 antibody; Apoptosis-stimulating of p53 protein 2 antibody; ASPP2 antibody; ASPP2_HUMAN antibody; BBP antibody; Bcl2 binding protein antibody; Bcl2-binding protein antibody; NY REN 51 antigen antibody; p53 binding protein 2 antibody; p53-binding protein 2 antibody; p53BP2 antibody; PPP1R13A antibody; Renal carcinoma antigen NY-REN-51 antibody; Tp53bp2 antibody; Tumor protein p53 binding protein 2 antibody; Tumor suppressor p53 binding protein 2 antibody; Tumor suppressor p53-binding protein 2 antibody
-
宿主:Rabbit
-
反應種屬:Human,Mouse
-
免疫原:Fusion protein of Human TP53BP2
-
免疫原種屬:Homo sapiens (Human)
-
標記方式:Non-conjugated
-
抗體亞型:IgG
-
純化方式:Antigen affinity purification
-
濃度:It differs from different batches. Please contact us to confirm it.
-
保存緩沖液:-20°C, pH7.4 PBS, 0.05% NaN3, 40% Glycerol
-
產品提供形式:Liquid
-
應用范圍:ELISA,WB,IHC
-
推薦稀釋比:
Application Recommended Dilution ELISA 1:2000-1:5000 WB 1:500-1:2000 IHC 1:50-1:200 -
Protocols:
-
儲存條件:Upon receipt, store at -20°C or -80°C. Avoid repeated freeze.
-
貨期:Basically, we can dispatch the products out in 1-3 working days after receiving your orders. Delivery time maybe differs from different purchasing way or location, please kindly consult your local distributors for specific delivery time.
-
用途:For Research Use Only. Not for use in diagnostic or therapeutic procedures.
相關產品
靶點詳情
-
功能:Regulator that plays a central role in regulation of apoptosis and cell growth via its interactions with proteins such as TP53. Regulates TP53 by enhancing the DNA binding and transactivation function of TP53 on the promoters of proapoptotic genes in vivo. Inhibits the ability of NAE1 to conjugate NEDD8 to CUL1, and thereby decreases NAE1 ability to induce apoptosis. Impedes cell cycle progression at G2/M. Its apoptosis-stimulating activity is inhibited by its interaction with DDX42.
-
基因功能參考文獻:
- Study have provided evidence that ASPP2 has an inhibitory influence on triplenegative breast cancer (TNBC) growth and metastasis, and that this may rely on using the PI3K/AKT pathway in a p53independent manner. PMID: 29568874
- the abnormal expression of ASPP2 may play an important role for development and metastasis in esophageal squamous cell carcinoma. PMID: 29747775
- These findings identify TP53BP2 as a strong candidate causative gene for central nervous system (CNS) defects in 1q41q42 microdeletion syndrome. PMID: 27447114
- Results showed that protein expression levels of ASPP2 and P53 were significantly higher in esophageal squamous cell carcinoma tissues than in paired noncancerous tissues. PMID: 28103919
- Expression levels of TP53BP2, FBXO28, and FAM53A genes were associated with patient survival specifically in ER-positive, TP53-mutated tumors. PMID: 28179588
- These data together implicated a critical impact of MiR-205/ASPP2 on promoting epithelial-mesenchymal transition. PMID: 27929537
- ASPP2 is a key regulator of BECN1-dependent autophagy. PMID: 27929538
- Our results suggest that Gal-1 and ASPP2 functionally compete in nanocluster for active Ras on the plasma membrane. ASPP2 dominates the biological outcome, thus switching from a Gal-1 supported growth-promoting setting to a senescence inducing and stemness suppressive program in cancer cells. Our results support Ras nanocluster as major integrators of tumour fate decision events. PMID: 27437940
- Downregulated expression of ASPP2 is associated with hepatocellular carcinoma. PMID: 27473084
- miR-548d-3p/TP53BP2 pathway is critically involved in the proliferation and apoptosis of breast cancer cells and may be new therapeutic target of breast cancer cells. PMID: 26663100
- ASPP1/2-PP1 complexes are required for chromosome segregation and kinetochore-microtubule attachments. PMID: 26595804
- ASSP2 expression is lower in cancerous tissues and decreased ASPP2 lead to higher cancer cells proliferation and autophagic flux, which contribute to the gemcitabine resistance. PMID: 26438046
- this study revealed a novel function of ASPP2 in modulating autophagy and apoptosis. PMID: 25534115
- ASPP2 may participate in the lipid metabolism of non-alcoholic steatohepatitis and attenuate liver failure. PMID: 25256142
- These results identify previously uncharacterized regions distributed throughout the protein sequence of ASPP2 as determinants of CagA binding, providing mechanistic insight into apoptosis reprogramming by CagA. PMID: 25963096
- ASPP2 directly induces the dephosphorylation and activation of junctional YAP PMID: 25360797
- CHOP is critical for mediating ASPP2-induced autophagic apoptosis by decreasing Bcl-2 expression and maintaining nuclear ASPP2-Bcl-2 complexes. PMID: 25032846
- ASPP1/2 interacted with centrosome linker protein C-Nap1. Co-depletion of ASPP1 and ASPP2 inhibited re-association of C-Nap1 with centrosome at the end of mitosis. PMID: 25660448
- these observations reveal that Itch and Yap1 have antagonistic roles in the regulation of ASPP2 protein stability through competing post-translational regulatory mechanism of ASPP2. PMID: 25436413
- phosphorylation of ASPP2 by RAS/MAPK pathway provides a novel link between RAS and p53 in regulating apoptosis PMID: 24312625
- Attenuated expression of apoptosis stimulating protein of p53-2 (ASPP2) in human acute leukemia is associated with therapy failure. PMID: 24312201
- higher rate Helicobacter pylori infection, an increased expression of inhibitor of apoptosis stimulating protein of p53 (iASPP), and decreased expression of apoptosis-stimulating of p53 protein 2(ASPP2) was present in gastric cancer PMID: 23528480
- our studies demonstrate the role of Siah2 in regulation of tight junction integrity and cell polarity under hypoxia, through its regulation of ASPP2 stability. PMID: 23644657
- Disruption of CagA and ASPP2 binding alters the function of ASPP2 and leads to the decreased survival of H. pylori-infected cells PMID: 24474782
- FIH-1 depletion did lead to impaired binding of Par-3 to ASPP2. PMID: 23606740
- We also unveiled a possible mechanistic link between ASPP2 and Csk/Src signaling pathway, implicating the multiple cellular functions of ASPP2. PMID: 23671128
- ASPP1 and ASPP2 cooperate with RAS to enhance p53-induced apoptosis suggests that loss of ASPP1 or ASPP2 expression may be a frequent event in human cancers with mutant RAS. PMID: 23392125
- When the Px(T)PxR motif is deleted or mutated via insertion of a phosphorylation site mimic (T311D), PP-1c fails to bind to all three ASPP proteins, ASPP1, ASPP2 and iASPP. PMID: 23088536
- ASPP2 binds to Ras-GTP at the plasma membrane and stimulates Ras-induced signaling and pERK1/2 levels via promoting Ras-GTP loading, B-Raf/C-Raf dimerization, and C-Raf phosphorylation. PMID: 23248303
- the mRNA expression of ASPP1 and ASPP2 was frequently dowregulated in tumor tissues, and this decreased significantly in samples expressing wild-type p53 PMID: 22552744
- Methylation in the promoter region of ASPP2 gene was not detected in lung cancer or adjacent non-neoplastic lung tissue. PMID: 22169642
- Helicobacter pylori cytotoxin-associated gene A (CagA) subverts the apoptosis-stimulating protein of p53 (ASPP2) tumor suppressor pathway of the host PMID: 21562218
- PP1A and ASPP2 play a critical role in promoting TAZ function by antagonizing the LATS kinase through TAZ dephosphorylation. PMID: 21189257
- study was to determine localization pattern of ASPP-2 in a variety of normal and malignant human tissues; study indicates that ASPP-2 has a specific distribution pattern within tissues and cells in a way that appears to be related to differentiation PMID: 21183427
- ASPP2(ANK-SH3) binds NFkappaB(p65) in a similar manner to its natural inhibitor IkappaB, suggesting a possible novel role for ASPP2 as an NFkappaB inhibitor PMID: 19507243
- ASPP1 and ASPP2 genes are frequently down-regulated by DNA methylation in HBV-positive hepatocellular carcinoma, which may play important roles in the development of HCC PMID: 20034025
- ASPP2 is a negative regulator of the neddylation pathway through specific interaction with APP-BP1 and suggest that dysfunction of the APP-BP1 interaction with APP may be one cause of Alzheimer's disease PMID: 12694406
- TP53BP2 encodes two mRNA species, either with (53BP2) or without exon 3 (ASPP2), by alternative splicing in various cell lines and tissues PMID: 14766226
- downstream of E2F, suggesting that it functions as a common link between the p53/p73 and Rb/E2F apoptotic pathways PMID: 15592436
- target of E2F transcription factor PMID: 15731768
- ASPP2 CpG island aberrant methylation could be one molecular and genetic alteration in wild-type p53 tumours. PMID: 15757645
- results suggest that the tumor protein p53 binding protein(TP53BP2) locus is associated with susceptibility to gastric cancer in the Korean population PMID: 15986435
- ASPP2/(53BP2L) expression regulation by proteasomal degradation modulates p53 apoptotic function PMID: 16091363
- In this study we explored the effect of NF-kappaB activation elicited by a physiological NF-kappaB inducer, interleukin-1beta (IL-1beta), and anti-apoptotic Bcl-2 family proteins on the 53BP2S-mediated apoptosis PMID: 16098144
- role of ASPP1, ASPP2, and iASPP as apoptotic specific regulators of p53 [review] PMID: 16139958
- suggest a possible role for the N-termini of ASPP proteins in binding to other proteins in the apoptotic response network PMID: 17594908
- 53BP2S interacts and modulates the insulin signals mediated by insulin receptor substrates. PMID: 17965023
- identifies the interaction sites of Bcl-2 and its homologues with ASPP2 PMID: 18719108
- bcl2 -938C/C genotype has worse prognosis and lower survival in patients with renal cell carcinoma. In addition, the bcl2 -938C/A single nucleotide polymorphism was shown to be an independent adverse prognostic factor for renal cell carcinoma PMID: 19539330
顯示更多
收起更多
-
亞細胞定位:Cytoplasm, perinuclear region. Nucleus. Note=Predominantly found in the perinuclear region. Some small fraction is nuclear. Sequester in the cytoplasm on overexpression of DDX42.
-
蛋白家族:ASPP family
-
組織特異性:Widely expressed. Expressed in spleen, thymus, prostate, testis, ovary, small intestine, colon and peripheral blood leukocyte. Reduced expression in breast carcinomas expressing a wild-type TP53 protein. Overexpressed in lung cancer cell lines.
-
數據庫鏈接:
Most popular with customers
-
-
YWHAB Recombinant Monoclonal Antibody
Applications: ELISA, WB, IHC, IF, FC
Species Reactivity: Human, Mouse, Rat
-
-
-
-
-
-